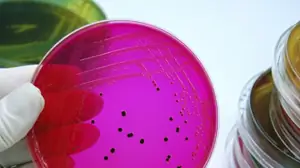
Image

Послушайте, как медицинский эпидемиолог CDC доктор Ян Пламб обсуждает инфекцию сальмонеллы в этой серии из пяти частей подкаста из внешнего консультанта. Темы включают симптомы, диагностические тесты, варианты лечения, последующее наблюдение за пациентами и устранение пробелов в знаниях.
оценки
По оценкам CDC, в Соединенных Штатах ежегодно из-за нетифозной сальмонеллы происходит около 1, 35 миллиона заболеваний и 420 смертей 1.
падение
FoodNet сообщает, что ежегодная заболеваемость сальмонеллезом в США составила 15, 2 заболевания на 100 000 человек 2.
тенденции
По сравнению с 2010-2012 гг. Частота нетифоидной инфекции сальмонеллы в 2013 г. снизилась на 9% 2. Посетите веб-сайт FoodNet для получения более подробной информации о самых последних тенденциях в инфекции сальмонеллы.
Факторы риска
- Инфекция сальмонеллы чаще встречается в летние месяцы (июнь, июль и август), чем зимой.
- Дети до 5 лет чаще всего заражаются сальмонеллезом 3.
- Дети, которые не вскармливаются грудью, чаще заражаются сальмонеллезом 4.
- Дети с 5 лет и моложе, взрослые старше 65 лет и люди с ослабленной иммунной системой наиболее подвержены тяжелым инфекциям.
- Некоторые лекарства (например, лекарства, снижающие кислотность желудка) могут увеличить риск заражения сальмонеллой 5.
Очаги
В 2012 году в CDC 6 было зарегистрировано 831 пищевая вспышка. Они были вызваны различными патогенными микроорганизмами, и 106 из них были подтверждены сальмонеллой. Сальмонелла была причиной большинства госпитализаций (64%) в случаях вспышек с подтвержденной причиной 6. В ходе крупнейшей недавней вспышки, в период с марта 2013 года по июль 2014 года, более 600 человек в 29 штатах и Пуэрто-Рико были инфицированы семью штаммами вспышки сальмонеллы Heidelberg 7. Эта вспышка была связана с одной маркой курицы, что привело к отзыву компанией более 40 000 фунтов куриных продуктов 8 и прекратилось после того, как компания ввела новые меры контроля для уменьшения загрязнения.
Определение и симптомы
Сальмонелла была открыта более века назад. Сальмонеллез, заболевание, вызванное сальмонеллой, в основном приводит к диарейной болезни от легкой до тяжелой степени, известной как острый гастроэнтерит.
симптомы
Симптомы острого гастроэнтерита из-за заражения сальмонеллой могут включать 9:
Основные условия:
Кишечнорастворимой: инфекция желудочно-кишечного тракта
Внекишечный: инфекция, происходящая вне кишечника
Гастроэнтерит: воспаление желудка и толстой и тонкой кишки, которое может привести к рвоте или диарее
Инвазивная инфекция: инфекция кровотока, костей, суставов, мозга или нервной системы
- Внезапное начало диареи (которая может быть кровавой)
- Брюшные судороги
- Лихорадка (почти всегда присутствует)
- Могут возникнуть тошнота, рвота и головная боль, хотя реже
Диарея может длиться несколько дней и приводить к потенциально сильному обезвоживанию, особенно у младенцев и детей в возрасте до 2 лет и у взрослых старше 65 лет. Даже после того, как клинические симптомы перестают быть очевидными, бактерии сальмонеллы могут обнаруживаться в кале в течение нескольких недель.
Большинство людей с диареей, вызванной сальмонеллезной инфекцией, полностью выздоравливают, хотя может пройти несколько месяцев, прежде чем их привычки кишечника станут полностью нормальными.
Иногда сальмонеллезная инфекция может распространяться на мочу, кровь, кости, суставы, мозг или нервную систему, вызывая симптомы, связанные с этой частью тела или системой. Некоторые из этих внеклеточных инфекций могут иметь долгосрочные последствия, в зависимости от того, какая часть тела заражена.
Инвазивные инфекции сальмонеллы
Когда инфекции сальмонеллы становятся инвазивными, они могут поражать кровоток, кость, сустав, мозг или нервную систему или другие внутренние органы.
Инвазивные инфекции сальмонеллы:
- Может быть серьезным и потенциально опасным для жизни.
- Встречаются примерно у 8 процентов людей с лабораторно подтвержденной инфекцией сальмонеллы. 10
-
Может происходить как:
- Бактериемия (заражение крови)
- Менингит (инфекция оболочек головного и спинного мозга)
- Остеомиелит (инфекция кости)
- Септический артрит (инфекция сустава).
- Редко приводят к летальному исходу, но чаще всего встречаются у людей очень молодого или пожилого возраста или с ослабленной иммунной системой.
Лечение и результаты
Подкасты от Консультанта 360
- Подкаст: варианты лечения сальмонеллезной инфекции icon
- Полная серия сальмонеллы подкастекстернальная икона
Как лечится сальмонеллез?
Давать жидкости очень важно. Устных жидкостей обычно достаточно, но людям с тяжелой диареей могут потребоваться внутривенные (IV) жидкости. Большинство людей не требуют антибиотиков.
См. Руководство по клинической практике Американского общества по инфекционным болезням 2017 года для диагностики и лечения инфекционной диареи> external icon
Следует ли лечить сальмонеллез антибиотиками?
Антибиотики НЕ рекомендуются для лечения большинства пациентов с сальмонеллезной инфекцией.
Антибиотики рекомендуются для
- Пациенты с ВИЧ-инфекцией.
- Другие пациенты с ослабленным иммунитетом (например, реципиенты органов с трансплантацией органов; те, кто получает кортикостероиды или другие иммунодепрессанты; те, кто болен раком или лимфопролиферативным заболеванием с текущей или недавней химиотерапией; и те, кто страдает серповидноклеточной анемией, гемоглобинопатиями или нарушениями ретикулоэндотелиальной системы, включая цирроз печени).
- Пациенты старше 50 лет с сердечными, клапанными или эндоваскулярными нарушениями или с существенными заболеваниями суставов.
- Люди с тяжелыми заболеваниями, такими как тяжелая диарея (от девяти до десяти стула в день), высокая или постоянная лихорадка или состояние, требующее госпитализации.
- Взрослые в возрасте 65 лет и старше.
У здоровых людей с инфекцией сальмонеллы антибиотики обычно не сокращают продолжительность болезни, диареи или лихорадки. Основными рисками лечения являются побочные эффекты антибиотика, возможность длительного бессимптомного носительства сальмонелл и нарушение микробиома. Ненужное использование антибиотиков также способствует устойчивости к антибиотикам.
CDC отслеживает инфекции сальмонеллы, которые устойчивы к антибиотикам через NARMS, Национальную систему мониторинга устойчивости к противомикробным препаратам.
Микробы, которые загрязняют пищу, могут быть устойчивыми из-за использования антибиотиков у людей и у пищевых животных. Мы можем предотвратить многие из этих инфекций, осторожно используя антибиотики и не допуская сальмонеллы в пищу, которую мы едим.
Что я должен знать о лечении пациентов с резистентными инфекциями сальмонеллы?
Если бактерии сальмонеллы устойчивы, антибиотики первого выбора, рекомендованные для лечения этих инфекций, могут не работать. Медицинским работникам может потребоваться назначить препараты второго или третьего выбора, но они могут быть менее эффективными, вводиться внутривенно, а не перорально, более токсично и дороже. Рекомендуемые антибиотики при тяжелых инфекциях включают фторхинолоны, азитромицин и цефалоспорины третьего поколения.
Как CDC отслеживает устойчивые инфекции сальмонеллы?
CDC отслеживает эти инфекции через Национальную систему мониторинга устойчивости к противомикробным препаратам (NARMS). Программа NARMS в CDC помогает защитить общественное здоровье, предоставляя информацию о возникающей резистентности бактерий, путях распространения резистентности и о том, чем резистентные инфекции отличаются от восприимчивых инфекций.
Узнайте больше о устойчивой сальмонелле с этими ресурсами от NARMS.
- NARMS Ежегодные отчеты о человеческих изолятах
- NARMS Now: интерактивная графика, отображающая данные об устойчивости к антибиотикам для сальмонеллы
- Публикации NARMS
Сальмонелла род и видовой фенотип: физические особенности организма
Серотип: группы в одном виде микроорганизмов, таких как бактерии или вирусы, которые имеют характерные поверхностные химические структуры
Род Salmonella является членом семейства Enterobacteriaceae. Как и другие Enterobacteriaceae, сальмонеллы являются грамотрицательными палочковидными палочками. Род Salmonella можно разделить на два вида (S. enterica и S. bongori) в зависимости от их фенотипического профиля. Юг кишечная палочка может быть далее разделена на шесть подвидов, используя их фенотипический профиль.
Наиболее распространенными серотипами сальмонеллы, вызывающими инфицирование человека, являются Enteritidis, Typhimurium, Newport и Javiana. На эти серотипы сальмонеллы приходится около половины культурно-подтвержденных изолятов сальмонеллы, зарегистрированных в лабораториях общественного здравоохранения 12.
Брюшной тиф и нетифоидная сальмонелла
Бактерии сальмонеллы классифицируются как «тифоидные» или «нетифоидные» в зависимости от их серотипа.
-
Тифозная сальмонелла относится к определенным серотипам сальмонеллы, которые вызывают брюшной тиф или паратифоз, включая Typhi, Paratyphi A, Paratyphi B (см. Примечание ниже) и Paratyphi C.
Серотип Paratyphi B является тартрат-отрицательным (не способен ферментировать тартрат) и вызывает брюшной тиф. Серотип Paratyphi B вар. L (+) тартрат + является тартрат-положительным (способен ферментировать тартрат) и вызывает нетифозное заболевание
- Нетифоидная сальмонелла относится ко всем другим серотипам сальмонеллы 13.
Источники инфекции
Как люди получают сальмонеллу?
Сальмонеллы живут в кишечных трактах людей и животных. Вы можете получить сальмонеллезную инфекцию из различных источников, в том числе:
- Употребление загрязненной пищи или питье загрязненной воды.
- Прикасаться к зараженным животным и не мыть руки потом.
Загрязненная пища или вода
Вы знали?
Человек, который находится в тесном контакте или в районе, где животные живут и бродят, может получить микробы на руках - даже если они не касаются животного напрямую.
Сальмонелла обычно передается человеку при употреблении в пищу продуктов, загрязненных небольшим количеством фекалий животных. Загрязненные продукты обычно выглядят и пахнут нормально. Они часто являются продуктами животного происхождения, такими как говядина, птица, молоко, рыба или яйца, но любая пища, включая овощи и фрукты или обработанные продукты, может быть загрязнена.
Пища также может быть загрязнена на кухне. Капли от сырого мяса или птицы могут загрязнить поверхности и другие продукты в холодильнике или корзине. Когда сырое мясо или птица готовятся с разделочной доской и ножом без тщательной промывки между употреблениями, они могут загрязнить другие продукты питания.
При приготовлении сырого мяса или птицы обработчики пищи могут переносить сальмонеллу на руках на другую пищу, если они не моют руки между этапами приготовления пищи. Работники, которые не моют руки после мытья в ванной, также могут загрязнять пищу сальмонеллой.
Контакт с зараженными животными
Сальмонеллы живут в кишечных трактах людей и других животных, в том числе домашней птицы и других птиц, земноводных и рептилий. Сальмонелла может быть обнаружена в кале некоторых животных, и люди могут заразиться, если они не моют руки после контакта с животными или фекалиями животных.
Многие животные могут нести микробы Salmonella, но выглядят совершенно здоровыми и чистыми. Тела животных, покрытые мехом, перьями или чешуей, могут быть загрязнены микробами. Рептилии, такие как черепахи, ящерицы и змеи, особенно вероятно укрывают сальмонеллу. Многие птенцы, утки и другая домашняя птица, в том числе в стадах на заднем дворе, могут переносить сальмонеллу в кале. Вы не можете посмотреть на животное и сказать, заражено ли оно сальмонеллой.
Область, где живет животное, например, его клетка или вода в аквариуме или места, где бродит животное, может быть загрязнена сальмонеллой, что может вызвать заболевание у людей, которые вступают в непосредственный контакт с областью животного, клеткой или аквариумом воды. Узнайте больше об инициативе CDC Healthy Pets Healthy People.
Сальмонелла Атлас
Атлас сальмонеллы в США, 1968-2011 гг. Pdf icon [PDF - 248 страниц] обобщает данные 42-летнего наблюдения за лабораторно подтвержденными изолятами сальмонеллы от человека. Атлас включает в себя:
- Анализ по возрасту, полу, географии и времени года
- Отчеты изолятов сальмонеллы от животных и связанных с ними источников (например, окружающей среды и кормов)
Это первый раз, когда CDC опубликовал эти данные онлайн в загружаемом формате. Вы можете скачать отчет полностью или в 32 отдельных отчетах серотипа Salmonella.
Чтобы получить больше информации:
- Сальмонелла Атлас
- 32 отдельных отчета серотипов
- Важность серотипирования
- Снимки серотипов
Системы наблюдения
CDC имеет несколько систем наблюдения для получения информации о сальмонелле. Они служат различным целям и предоставляют информацию о различных особенностях эпидемиологии организма, таких как количество вспышек, устойчивых к противомикробным препаратам инфекций и подтипов.
Национальный обзор эпиднадзора за сальмонеллой
Национальный эпиднадзор за сальмонеллой проводится через лаборатории общественного здравоохранения в случаях, подтвержденных культурой, и через Национальную систему эпиднадзора за заболеваниями (NNDSS). На сайтах FoodNet ведется активный лабораторный и популяционный надзор. Узнайте больше о эпиднадзоре за сальмонеллой pdf icon [PDF - 12 страниц].
Данные:
Ежегодные таблицы сводок и данных: сводные данные об инфекциях сальмонеллы, собранных с помощью пассивного наблюдения
Система эпиднадзора за вспышками болезней пищевого происхождения (FDOSS) собирает данные о патогенных агентах, продуктах питания и местах, ответственных за вспышки.
Интернет сайт:
- Система эпиднадзора за вспышками болезней пищевого происхождения (FDOSS)
- Национальная система отчетности о вспышках (NORS)
- NORS Панель инструментов
Данные:
Ежегодные отчеты
Сеть активного эпиднадзора за болезнями пищевого происхождения (FoodNet) сообщает о тенденциях в отношении пищевых инфекций и отслеживает влияние политики безопасности пищевых продуктов.
Интернет сайт:
- Сеть активного наблюдения за болезнями пищевого происхождения (FoodNet)
- Программа новых инфекций CDC
Данные:
- Отчеты о наблюдении: годовые отчеты FoodNet
- Исследования и Обзоры: Исследования и Обзоры FoodNet
Лабораторное наблюдение за кишечными заболеваниями (LEDS) собирает информацию об изолятах сальмонеллы, вызывающих инфицирование человека, включая серотипирование, чтобы помочь оценить географические различия и долгосрочные тенденции
Интернет сайт:
- Лабораторное наблюдение за кишечными заболеваниями (LEDS)
- Лаборатория кишечных заболеваний (EDLB)
Данные:
- Обзор эпиднадзора за сальмонеллой pdf icon [PDF - 12 страниц]
- Ежегодные сводки по эпиднадзору за сальмонеллой
- Сальмонелла Атлас
Национальная система мониторинга устойчивости к противомикробным препаратам - кишечные бактерии (NARMS) контролируют и сообщают об устойчивости к противомикробным препаратам кишечных бактерий, включая сальмонеллу, от человека, мясных продуктов и животных
Интернет сайт:
- Национальная система мониторинга устойчивости к противомикробным препаратам - кишечные бактерии (NARMS)
- Министерство сельского хозяйства США (внешняя икона USD)
- Управление по контролю за продуктами и лекарствами (FDAexternal icon)
Данные:
- NARMS Human Isolates Reports (CDC )
- NARMS Retail Meat Isolatesexternal icon Отчеты и межведомственные исполнительные отчетыsexternal icon (FDA)
- NARMS Изолят для животных внешний значок Отчеты (USDA)
Национальная сеть молекулярного субтипирования для эпиднадзора за болезнями пищевого происхождения (PulseNet) объединяет случаи заболевания по всей стране для быстрого выявления вспышек, включая многие, которые в противном случае остались бы незамеченными.
Интернет сайт:
- PulseNet
- Ассоциация лабораторий общественного здравоохранения (APHLexternal icon)
- Импульсный гель-электрофорез (PFGE)
- PulseNet Internationalexternal icon
- PulseNet следующего поколения
Данные:
Публикации
Национальная система эпиднадзора за болезнями, подлежащими уведомлению (NNDSS), отслеживает заболевания, подлежащие регистрации, по всей территории Соединенных Штатов.
Интернет сайт:
- Национальная система эпиднадзора за болезнями, подлежащими уведомлению (NNDSS)
- Сбор данных и отчетность
Данные:
- Ежегодные итоги 1993-2010
- Еженедельные сводки: подсчеты штатов и территорий
Верх страницы
Ссылки
- CDC. Угрозы устойчивости к антибиотикам в Соединенных Штатах, 2019. Атланта, Джорджия: Министерство здравоохранения и социальных служб США, CDC; 2019.
- CDC. Заболеваемость и тенденции заражения патогенными микроорганизмами, которые обычно передаются через сеть активного эпиднадзора за болезнями пищевого происхождения, 10 сайтов США, 2006-2013 гг. MMWR Morb Mortal Wkly Rep. 2014; 63 (15); 328-332
- CDC. Сеть активного эпиднадзора за болезнями пищевого происхождения (FoodNet): Отчет об эпиднадзоре FoodNet за 2012 г. (итоговый отчет) pdf icon [PDF - 53 страницы]. Атланта, штат Джорджия: Министерство здравоохранения и социальных служб США, CDC. 2014.
- Джонс Т. Ф. и соавт. Контрольное исследование эпидемиологии спорадической сальмонеллезной инфекции у детей грудного возраста. Педиатрия. 2006; 118 (6): 2380-2387.
- Bavishi C, DuPont HL. Систематический обзор: использование ингибиторов протонной помпы и повышение восприимчивости к кишечной инфекции. Пищевая фармакология и терапия. 2011; 34 (11-12): 1269-1281.
- CDC. Эпиднадзор за вспышками болезней пищевого происхождения, США, 2012 г., годовой отчет pdf icon [PDF - 20 страниц]. Атланта, Джорджия: Министерство здравоохранения и социальных служб США, CDC, 2014.
- CDC. Многоуровневая вспышка инфекций сальмонеллы Гейдельберга с множественной лекарственной устойчивостью, связанных с курой бренда Foster Farms. 2014.
- ФССН. Калифорнийский оптовый магазин отзывает продукты из куриного гриля из-за возможного заражения сальмонеллой Гейдельберг. 2013.
- Американская ассоциация общественного здравоохранения. Руководство по борьбе с инфекционными заболеваниями, 19-е издание, Официальный отчет Американской ассоциации общественного здравоохранения. 19-е издание. 2008.
- CDC, Национальные данные эпиднадзора за сальмонеллой, неопубликованные, 2013
- Центры по контролю и профилактике заболеваний (CDC). Устойчивые к антибиотикам угрозы в США, 2015 г. Атланта, штат Джорджия: Министерство здравоохранения и социальных служб США, CDC, 2015.
- CDC. Сеть активного эпиднадзора за болезнями пищевого происхождения (FoodNet): Отчет об эпиднадзоре FoodNet за 2012 г. (итоговый отчет) pdf icon [PDF - 36 страниц]. Атланта, штат Джорджия: Министерство здравоохранения и социальных служб США, CDC. 2014.
- Реактивный артрит после кишечных инфекций в США: проблема определения. Таунс JM. Clin Infect Dis. 2010 янв. 15; 50 (2): 247-54.
